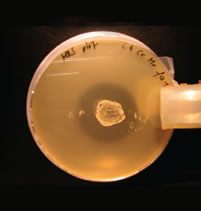

|
|||||||||||||
Newly developed defined CE product PoultryStar® soon to be launchedUndefined CE preparations to increase the colonization resistance of chicks against Salmonella or other pathogens are already available in non European markets. They are usually preparations originating from cecal content and pose the risk, due to their unknown bacterial composition, that they can contain pathogenic bacteria or viruses for poultry and or humans. In a defined CE preparation the inclusion of any potential avian or human pathogens can be avoided. Biomin has put a lot of effort into the development of a defined CE product for poultry consisting of a blend of beneficial bacteria isolated from healthy chicken. What is Competitive Exclusion?  Figure 1: Competitive Exclusion Competitive exclusion (CE) is a term to describe the process by which beneficial bacteria in the gastrointestinal tract exclude pathogenic microorganism. CE mechanisms are still not fully understood but following modes of action are proposed in literature. A physical competition for attachment sites occurs on the gut wall, where normal gut bacteria adhere to the mucosa to occupy receptors, which can also be used by pathogenic bacteria, blocking the establishment of transient pathogenic bacteria (figure 1). Furthermore the pH is reduced in the intestine through increased production of volatile fatty acids (VFA) and lactate. Antibacterial substances like bacteroicins are produced and a competition for nutrients takes place. What are Probiotics? Probiotics are defined as „Live microbial feed supplements” which beneficially affect the host animal by improving its intestinal microbial balance. Probiotic bacteria are selected for their potential to provide specific health or nutritional effects to the animal. Strategies are aimed towards stimulation of the growth of beneficial bacteria and suppression of potentially harmful microorganisms. Probiotics are health-promoting microorganisms that are useful for protection against infection. Scientific background of PoultryStar® For the development of PoultryStar® intensive research work in our own laboratories and in collaboration with several universities and partners from industry was carried out. The research work was supported by the Commission of the European Union. Isolation and characterization of suitable strains The product development process started with the isolation of intestinal bacteria out of the gut of several healthy chickens, thus providing a rationale for their safe use as a feed additive for poultry. To obtain the most efficient strains, it was decided to use intestinal contents of different origin, selecting chicken of different ages and genotype. A pool of diverse aerobic, facultative anaerobic and obligate anaerobic gut bacteria was isolated out of four main intestinal compartments – the crop, jejunum, ileum and the cecum – using a wide variety of conventional microbiological cultivation techniques (figure 2). Pure cultures of isolates were stored for further investigations and thoroughly characterized with regard to their metabolic properties, growth and fermentation performance, adaptability to industrial processes, stability in the end product and inhibitory activities.  Figure 2: Isolation auf intestinal bacteria Evaluation of suitable strains The most promising strains were evaluated for important probiotic criteria such as adhesion to intestinal cell walls, inhibition of pathogens, range of metabolic end products, fermentation performance, stability against acids and bile salts, storage stability and safety status. In order to investigate the adhesion ability of various isolates to intestinal cells a tissue culture test system was used. The received results clearly showed the ability of several isolates to attach to intestinal cells in vitro. A co-cultivation agar plate assay was used to test the isolates for their ability to inhibit the growth of pathogens like Salmonella enteritidis, Salmonella typhimurium, Salmonella choleraesuis, Campylobacter jejuni, E. coli and Clostridium perfringens (figure 3). Several isolates had the ability to inhibit pathogenic strains and the results showed furthermore that the inhibition potential of single strains against the pathogens was quite different (figure 4). Figure 3: Isolate with the ability to inhibit Salmonella  Figure 4: Ability of product strains to inhibit pathogenic bacteria On the basis of the collected results, it was decided to combine five very promising chicken strains of different species affiliation from the crop, jejunum, ileum and cecum of broilers to design a multispecies product. Selected strains for PoultryStar® The following probiotic strains were selected for the product due to their superior features
With regard to the type of fermentative metabolism the strains were affiliated to three major groups of lactic acid producers: 1) strict homofermentative LAB (E. faecium, P. acidilactici, L. salivarius) generating lactate as the sole product of fermentation 2) strict heterofermentative LAB (L. reuteri) producing a mixture of ethanol, acetate and lactate 3) heterofermentative bifidobacteria (B. animalis) producing acetate and lactate. Safety assessment was an essential phase in the development of the probiotic feed additive fo Biomin. Each single strain of the final product was carefully evaluated for safety. Furthermore an economic fermentation process with highest quality standards for the production of the selected product strains was developed (figure 5).  Figure 5: Fermenter Besides the five probiotic strains PoultryStar® contains the prebiotic inulin which selectively stimulates the growth of Bifidobacteria and immune-modulating cell wall fragments that enhance the weak innate immune system of day old chicks and furthermore improve the infection resistance in the gut. The efficacy of PoultryStar® in improving performance parameters and Competitive Exclusion of Salmonella have already be confirmed in several feeding trials. For Further Product Information Please Visit www.biomin.net |
Featured Products PoultryStar®Naturally ahead in poultry gut health!Related Articles PoultryStar®:Defined probiotic product – proves efficacy PoultryStar®:Newly developed defined CE product PoultryStar® soon to be launchedAsk The Experts Ask The ExpertsOur poultry experts answer your questions.Related Services Mycotoxin ChannelWorld renowned experts answer mycotoxin related questions. Mycotoxins.infoA wealth of Mycotoxin information at your fingertips. World Nutrition ForumThe future of animal nutrition B.R.A.I.N ProgramBiomin Research and Innovation Network |
||||||||||||
|
BIOMIN Holding GmbH Industriestrasse 21, 3130 Herzogenburg, Austria/Europe ATU56585323
Tel.: +43 2782 803, Fax: +43 2782 803 30 e-mail:[email protected] |
|||||||||||||


 © 2000 - 2021. Global Ag MediaNinguna parte de este sitio puede ser reproducida sin previa autorización.
© 2000 - 2021. Global Ag MediaNinguna parte de este sitio puede ser reproducida sin previa autorización.